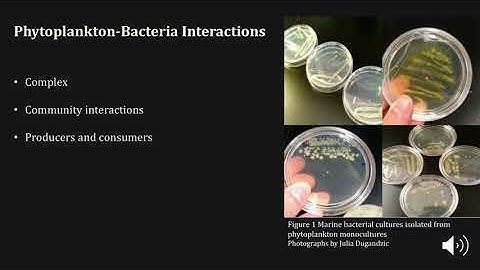
Interaction and Vitamin Exchange in Marine Microbial Communities

⬇ DOWNLOAD NOW
Kalau muncul iklan pop-up, tutup lalu klik tombol kembali
Download lagu Interactions in microbial communities: Introduction secara gratis hanya untuk keperluan promosi. Dukung artis favorit kamu dengan membeli musik original di iTunes atau platform resmi lainnya.
 Microbial interactions: Microbial communities of cheese rinds
Microbial interactions: Microbial communities of cheese rinds
 Microbial Communities In Nature & Laboratory - Interview l Protocol Preview
Microbial Communities In Nature & Laboratory - Interview l Protocol Preview
 Overview of microbial community studies
Overview of microbial community studies
 Microbial Interaction|Mutualism|Cooperation|Commensalism|Amensalism|Parasitism|Predation|Competition
Microbial Interaction|Mutualism|Cooperation|Commensalism|Amensalism|Parasitism|Predation|Competition
 Understanding Interactions in Microbial Populations
Understanding Interactions in Microbial Populations
 Biofilm Biology: Understanding Microbial Communities (8 Minutes)
Biofilm Biology: Understanding Microbial Communities (8 Minutes)
Interaction and Vitamin Exchange in Marine Microbial Communities
Interaction and Vitamin Exchange in Marine Microbial Communities
 Introduction to Microbe Host Interactions.mp4
Introduction to Microbe Host Interactions.mp4